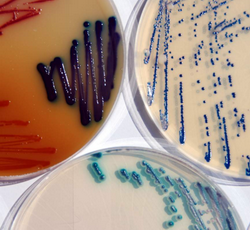

Питательные среды
Брошюры
Все файлы в формате PDF. Для просмотра файлов используйте Adobe Reader.
Milliflex насос+система ускоренного микробиологического контроля
Гравиметрические дилютеры DiluCult
Гребенка EZ-Fit Manifold для лабораторной фильтрации
Лабораторный гомогенизатор ESH
Микробиологические воронки EZ-Fit
Насос для контроля стерильности Steritest Symbio(autosave)
Насос для контроля стерильности Steritest Symbio
Питательные среды для валидации процесса наполнения MediaFills Pharma
Питательные среды Мерк + добавки с кат.номерами
Пробоотборник воздуха RCS High Flow Touch
Широкий выбор питательных сред: сухие гранулированные (соответствие госфармакопеи РБ) в объёмах по 500 гр 5 кг, 10 кг, готовые во флаконах (100, 200 мл), в ампулах (2 мл), чашках Петри (с выпуклой поверхностью). Компания MERCK имеет патент на технологию выпуска питательных сред в гранулах, срок годности – до 5 лет. Важным преимуществом является то, что сухие среды не пылят, вследствие чего не вызывают аллергических реакций и оставляют рабочее место в чистоте.
-питательные среды для культивирования микроорганизмов
-питательные среды для приготовления разведений образцов
-питательные среды для подсчёта численности микроорганизмов
-питательные среды для требовательных микроорганизмов
- питательные среды для дрожжей и плесеней, колиформных бактерий, определения листерий, бацилл и других микроорганизмов.
Сухие питательные среды Merck:
Питательные среды для подсчета численности микроорганизмов
|
Кат.№ |
Наименование |
Кол-во, г/уп |
Расход среды, г/л |
|
10546З |
Plate count agar- Питательный агар для подсчета ОМЧ |
500 |
22,5 |
|
115ЗЗ8 |
Plate count agar+skim milk - Питательный агар с обезжиренным молоком; среда для подсчета ОМЧ |
500 |
20,0 |
|
105458 |
CASO agar- Триптиказо-соевый агар |
500 |
40,0 |
|
107З24 |
Tryptic soy agar with polysorbate 80 and lecithin - Триптиказо-соевый агар с Твином 80 и лецитином для контроля дезинфекции |
500 |
45,7 |
|
110404 |
Letheen Agar- Летиновый агар для подсчета микроорганизмов в присутствии дезинфектантов или ингибиторов (например, косметика) |
500 |
52,1 |
|
100416 |
R2A agar- Агар для подсчета микроорганизмов в воде |
500 |
15,2 |
|
11З116 |
Yeast extract agarISO 6222 - Дрожжевой экстракт агар для подсчета микроорганизмов в воде, ИСО 6222 |
500 |
35,0 |
Питательные среды для культивирования микроорганизмов
|
Кат.№ |
Наименование |
Кол-во, г/уп |
Расход среды, г/л |
|
105459 |
Tryptic soy CASO broth – Триптиказо-соевый питательный бульон |
500 |
30,0 |
|
105443 |
Nutrient broth - Питательный бульон |
500 |
8,0 |
|
111723 |
Casein-peptone Lecithin Polysorbate Broth (TAT Broth) - ТАТ-бульон; среда для разведения образцов косметики; пептон из казеина, лецитин, твин 20 |
500 |
25,0 |
|
110405 |
Letheen Broth – Летиновый бульон для обнаружения микроорганизмов в присутствии дезинфектантов или ингибиторов (например, косметика) |
500 |
37,6 |
Питательные среды для требовательных микроорганизмов
|
Кат.№ |
Наименование |
Кол-во, г/уп |
Расход среды, г/л |
|
110676 |
Tryptose broth – Триптозный бульон для обогащения и культивирования требовательных патогенных микроорганизмов |
500 |
26 |
|
110493 |
Brain-heart broth – Бульон с сердечно-мозговой вытяжкой для культивирования требовательных патогенных микроорганизмов |
500 |
37,0 |
|
113825 |
Brain heart agar – Агар с сердечно-мозговой вытяжкой для культивирования требовательных патогенных микроорганизмов |
500 |
52,0 |
|
110455 |
Columbia agar base – Основа Колумбийского агара для культивирования требовательных микроорганизмов |
500 |
42,0 |
|
110328 |
Blood agar base – Основа кровяного агара |
500 |
40,0 |
Питательные среды для определения колиформных бактерий и E. coli
|
Кат.№ |
Наименование |
Кол-во, г/уп |
Расход среды, г/л |
|
105394 |
Enterobacteriaceae enrichment broth (EE-Broth) – Селективный бульон для энтеробактерий |
500 |
45,0 |
|
110620 |
Fluorocult LMX Broth – Хромогенная среда на колиформы и E.coli в сырье и готовой продукции смывах |
500 |
17,0 |
|
105454 |
BRILA broth – Лактозный бульон с бриллиантовым зеленым и желчью |
500 |
40,0 |
|
105396 |
MacConkey broth – бульон Мак-Конки |
500 |
35,0 |
|
110266 |
Lauryl sulfate broth – Лаурил-сульфатный бульон |
500 |
35,6 |
|
101298 |
Readycult Coliforms 100 – Хромогенная среда на колиформы и E.coli, наличие/отсутствие в 100 мл воды |
20 тестов |
|
|
110426 |
Chromocult Coliform Agar – Хромогенный агар для определения колиформ и E.coli в воде и напитках |
500 |
26,5 |
|
100898 |
E.coli/ Coliform Selective-Supplement – Селективная добавка для подавления сопутствующей микрофлоры |
16 фл |
|
|
100850 |
Chromocult Coliform Agar ES – Хромогенный агар для определения колиформ и E.coli в продуктах и сырье |
500 |
33,5 |
|
110275 |
VRBD agar – Глюкозный агар с кристаллическим фиолетовым и желчью |
500 |
39,5 |
|
101406 |
VRB Agar – Лактозныйагар с кристаллическим фиолетовым и желчью |
500 |
39,5 |
|
105465 |
MacConkey agar – Агар Мак-Конки |
500 |
39,0 |
|
104044 |
Endo agar - Агар Эндо |
500 |
39,0 |
|
107680 |
Lactose TTC Agar Tergitol – Лактозный агар ТТХ с тергитолом |
500 |
53,9 |
|
110859 |
Tryptone water - Триптоновая вода, тест на образование индола |
500 |
15 |
|
109293 |
KOVAC Indole reagent – Реагент Ковача на индол |
100 мл |
|
|
113300 |
Bactident Oxidase – Оксидазный тест |
50 шт. |
|
Питательные среды для определения дрожжей и плесневых грибов
|
Кат.№ |
Наименование |
Кол-во, г/уп |
Расход среды, г/л |
|
108339 |
SABOURAUD-2% dextrose broth – Бульон Сабуро 2% декстрозы |
500 |
30,0 |
|
116000 |
YGC agar – Селективный агар с хлорамфениколом на дрожжи и плесневые грибы |
500 |
40,0 |
|
105438 |
SABOURAUD-4% dextrose agar – Агар Сабуро 4% глюкозы |
500 |
65,0 |
|
100467 |
RBC agar- Селективный агар розовый бенгальский с хлорамфениколом (контроль воздуха) |
500 |
32,2 |
|
100465 |
Dichloran Glycerol agar (DG 18) – Дихлоран глицерол агар, дихлоран препятствует разрастанию плесеней |
500 |
31,6 |
|
110130 |
Potato dextrose agar – Картофельный глюкозный агар |
500 |
39,0 |
|
105398 |
Malt extract agar- Агар с солодовым экстрактом |
500 |
48,0 |
|
105397 |
Malt extract broth – Солодовый бульон |
500 |
17,0 |
|
105448 |
Wort agar – Сусло-агар |
500 |
55,0 |
|
105449 |
Wort broth base – Основа сусло-бульона |
500 |
33,0 |
|
107315 |
SABOURAUD-2% dextrose agar – Агар Сабуро 2% глюкозы для культивирования дерматофитов |
500 |
47,0 |
|
105460 |
CZAPEK-DOX agar – Среда Чапека-Докса |
500 |
48,0 |
Питательные среды для определения сальмонелл
|
Кат.№ |
Наименование |
Кол-во, г/уп |
Расход среды, г/л |
|
107228 |
Peptone water buffered – Пептонная вода забуференная |
500 |
25,5 |
|
107228 |
Peptone water buffered – Пептонная вода забуференная |
5000 |
25,5 |
|
107717 |
Selenite enrichment broth – Селенитовый накопительный бульон |
500 |
23,0 |
|
107709 |
Selenite cystin eenrichment broth – Селенит-цистиновый накопительный бульон |
500 |
23,0 |
|
110863 |
Tetrathionate enrichment broth Muller-Kauffman – Тетратионатный бульон Мюллера-Кауфмана |
500 |
82,0 |
|
105878 |
Muller-Kauffmann Tetrathionate-Novobiocin Broth (MKTTn) – Тетратионатный бульон с новобиоцином |
500 |
89,5 |
|
110236 |
Salmonella enrichment broth RAPPAPORT – Магниевая среда Раппапорта |
500 |
54,0 |
|
107700 |
Salmonella enrichment broth RAPPAPORT-VASSILIADIS (RVS) – Магниевая среда Раппапорт-Вассилиадиса |
500 |
43,0 |
|
109878 |
MSRV (Modified semi-solid Rappaport-Vassiliadis) –Полужидкая модифицированная среда Раппапорта-Вассилиадиса для ускоренного выделения сальмонелл из продуктов и сырья |
500 |
31,6 |
|
109874 |
MSRV Selective Supplement – Селективная добавка (новобиоцин, 10 мг) к среде MSRV |
16 фл. |
|
|
110153 |
Salmosyst broth base – Бульон для неселективного обогащения сальмонелл |
500 |
25,0 |
|
110141 |
Salmosyst selective tablets – Селективное обогащение сальмонелл– Тетратионатная среда в таблетках |
250 опред. |
|
|
107500 |
Rambach agar – Хромогенный Рамбах агар на сальмонеллы на 250 опред. |
4×250 мл |
|
|
113919 |
XLT4 agar- Ксилозо-лизиновый агар с тергитолом 4 (полностью ингибирует роста протея) |
500 |
|
|
108981 |
XLT4 Supplement- Селективная добавка к среде XLT4 агар |
100 мл |
|
Singlepath Salmonella - экспресс-тест для определения сальмонелл
|
Кат.№ |
Наименование |
Кол-во, г/уп |
|
104140 |
Singlepath Salmonella – Экспресс-тест (20 мин) на сальмонеллы |
25 тестов |
Дифференциально-диагностические среды для сальмонелл
|
Кат.№ |
Наименование |
Кол-во, г/уп |
Расход среды, г/л |
|
105418 |
Bismuth sulfite agar WILSON-BLAIR – Висмут-сульфитный агар |
500 |
47,5 |
|
105287 |
XLD-агар – Ксилозо-лизин-дезоксихолатный агар для выделения и диффернциации патогенных энтеробактерий |
500 |
55,0 |
|
111681 |
Hektoen enteric agar – Гектоеновый агар |
500 |
75,0 |
|
107667 |
SS-agar – Сальмонелла-шигелла агар |
500 |
60,0 |
|
107232 |
BPLS (Brilliant-green Phenol-red Lactose Sucrose Agar) - Лактозо-сахарозный агар с бриллиантовым зеленым и феноловым красным |
500 |
51,0 |
|
103913 |
KLIGLER agar- Агар Клиглера; двухсахарный агар с железом |
500 |
55,0 |
|
103915 |
Triple sugar iron agar – Трехсахарный агар с железом |
500 |
65,0 |
|
111640 |
Lysine iron agar – Лизиновый агар с железом для дифференциации и идентификации энтеробактерий; определение лизиндекарбоксилазы и сероводорода |
500 |
32,00 |
|
105712 |
MR-VP broth Methylred-VOGES-PROSKAUER broth – Среда для постановки реакций с метиловым красным и реакции Фогес-Проскауэра |
500 |
17,0 |
|
110282 |
OF basal medium Hugh and Leifson – Среда Хью-Лейфсена для дифференциации энтеробактерий бактерий - реакция окисления / ферментации углеводов |
500 |
11,0 |
|
102501 |
SIMMONS citrate agar – Цитратный агар Симмонса |
500 |
22,5 |
Питательные среды для определения листерий
|
Кат.№ |
Наименование |
Кол-во, г/уп |
Расход среды, г/л |
|
110824 |
UVM-Listeria selective enrichment broth – Селективный бульон для первичного обогащения листерий; включает селективные добавки |
500 |
54,5 |
|
104039 |
UVMII supplement – Селективная добавка для второго этапа накопления листерий |
1 фл. |
|
|
110398 |
FRASER Listeria Selective Enrichment Broth – Основа бульона Фразера |
500 |
55,0 |
|
100092 |
Fraser Listeria Ammonium Iron (III) Supplement – Добавка цитрата аммонийного железа для среды Фразера |
10 фл |
|
|
100093 |
FRASER Listeria Selective selective supplement – Добавка к среде Фразера |
10 фл |
|
|
100427 |
Chromocult Listeria selective agar base acc. Ottaviani and Agosti (IS0 11290) – Хромогенный агар (основа) для определения листерий по Оттавиани-Агости |
500 |
70 |
|
100432 |
Chromocult Listeria agar selective supplement – Селективная добавка к хромогенному агару |
10 фл. |
|
|
100439 |
Chromocult Listeria agar enrichment supplement – Обогатительная добавка к хромогенномуагару |
10 фл. |
|
|
111755 |
PALCAM Listeria selective agar base - Основа среды ПАЛКАМ для листерий |
500 |
69,0 |
|
112122 |
PALCAM Listeria Selective-Supplement – Добавка к среде ПАЛКАМ |
16фл. |
|
|
104148 |
Singlepath L’mono – Экспресс-тест (20 мин) на Listeria monocytogenes |
25 тестов |
|
Питательные среды для определения золотистого стафилококка
|
Кат.№ |
Наименование |
Кол-во, г/уп |
Расход среды, г/л |
|
110675 |
Giolitti-Cantoni broth base – Основа селективного бульона для обогащения стафилококка |
500 |
55,0 |
|
107899 |
Staphylococcus Enrichment Broth base – Бульон для селективного обогащения стафилококков |
500 |
43,0 |
|
105406 |
BAIRD-Parker agar – Агар Байрд-Паркер |
500 |
58,0 |
|
10З785 |
Egg yolk tellurite emulsion (sterile) – Стерильная желточно-теллуритная эмульсия |
10×50мл |
|
|
105404 |
Mannitol salt phenol-red agar – Маннитол-солевой агар с феноловым красным |
500 |
108,0 |
Питательные среды для определения Bacillus сereus
|
Кат.№ |
Наименование |
Кол-во, г/уп |
Расход среды, г/л |
|
105267 |
Cereus selective agar MOSSEL (M.Y.P.-agar) – Селективный агар Мосселя |
500 |
43,0 |
|
109875 |
Bacillus cereus selective supplement – Селективная добавка к среде Мосселя |
16 фл. |
|
|
103784 |
Egg-yolk (sterile) - Желточная эмульсия стерильная |
10×100 мл |
100,0 |
|
104146 |
Doupath Cereus Enterotoxins – Экспресс-тест (30 мин) на энтеротоксины B.cereus |
25 тестов |
|
|
101868 |
Casein hydrolysate Glucose Yeast Extract Broth (Base) – Основа бульона для синтеза энтеротоксинов B.cereus |
100 |
51,0 |
Агар для выделения и подсчета бацилл
|
Кат.№ |
Наименование |
Кол-во, г/уп |
Расход среды, г/л |
|
110860 |
Dextrose Casein-peptone agar – Агар для выделения и подсчета бацилл |
500 |
27,0 |
Определение синегнойной палочки
|
Кат.№ |
Наименование |
Кол-во, г/уп |
Расход среды, г/л |
|
105284 |
Cetrimide agar – Цетримидный агар |
500 |
44,5 |
|
110329 |
Malachite-green broth - Бульон с малахитовым зеленым |
500 |
8,4 |
Питательные среды для определения лактобацилл
|
Кат.№ |
Наименование |
Кол-во, г/уп |
Расход среды, г/л |
|
110661 |
MRS broth – MRS-бульон |
500 |
52,2 |
|
110660 |
MRS agar – MRS-агар |
500 |
66,2 |
|
105413 |
Rogosa-agar – Рогоза-агар |
500 |
74,5 |
|
110673 |
Orange serum agar – Агар с апельсиновым экстрактом |
500 |
42,0 |
|
115029 |
M17 broth – M17 бульон для молочнокислых стрептококков |
500 |
42,5 |
|
115108 |
M17 agar – M17 агар для молочнокислых стрептококков |
500 |
55,0 |
|
110453 |
АРТ-agar – АРТ-агар для выявления гетероферментативных лактобацилл (Leuconostoc) |
500 |
59,5 |
Питательные среды для определения энтерококков
|
Кат.№ |
Наименование |
Кол-во, г/уп |
Расход среды, г/л |
|
105262 |
Membrane-filter Enterococcus Selective agar acc. to SLANETZ and BARTLEY – Селективный агар Сланетца- Бертли для энтерококков |
500 |
41,5 |
|
105222 |
Kanamycin Esculin Azide agar – Агар с канамицином, эскулином и азидом натрия |
500 |
47,5 |
|
101299 |
Readycult Enterococci 100 – Хромогенный бульон на энтерококки, наличие/отсутствие в 100 мл воды |
20 тестов |
|
|
101590 |
Azide dextrose broth – Азид глюкозный бульон |
500 |
35,0 |
|
110294 |
Chromocult Enterococci broth – Хромогенный бульон на энтерококки |
500 |
18,0 |
|
1030З2 |
Bromocresol-purple Azide broth – Бульон с бромкрезоловым пурпурным и азидом натрия |
500 |
36,0 |
|
100072 |
Bile Salt Aesculin Azide agar – Агар с эскулином и желчью |
500 |
54,7 |
|
100950 |
Chromocult Enterococci agar – Хромогенный агар на энтерококки |
500 |
33,0 |
|
110707 |
KF Streptococcus agar – KF агар для стрептококков |
500 |
71,5 |
Питательные среды для определения бифидобактерий
|
Кат.№ |
Наименование |
Кол-во, г/уп |
Расход среды, г/л |
|
100043 |
TOS Propionate Agar (Base) – TOS пропионатный агар (основа) |
500 |
62,5 |
|
100045 |
MUP Selective Supplement – MUP селективная добавка |
10 фл. |
1/500мл |
Системы для создания анаэробных условий культивирования
|
Кат.№ |
Наименование |
Кол-во, шт/уп |
|
116387 |
Anaero jar – Анаэростат, объем 2,5 л |
1 |
|
107040 |
Petri-dish rack – Штатив для 12 чашек Петри для анаэростата |
1 |
|
115112 |
Anaerotest – индикатор анаэробых условий |
50 |
|
116275 |
Anaerocult-С – газпак для создания повышенной концентрации СO2 |
25 |
|
113829 |
Anaerocult-A – газпак для создания анаэробных условий |
10 |
|
114226 |
Anaeroclip – клипсы для пакетов |
25 |
|
101611 |
Anaerocult-A mini – газпак для создания анаэробных условий, 1-4 чашки Петри |
25 |
|
113682 |
Anaerocult-C mini – газпак для создания атмосферы с повышенной концентрацией СO2 1-4 чашки Петри |
25 |
|
113807 |
Anaerocult® P – набор для создания анаэробных условий в одной чашке Петри |
25 |
Питательные среды для определения сульфитредуцирующих клостридий
|
Кат.№ |
Наименование |
Кол-во, г/уп |
Расход среды, г/л |
|
111699 |
Diferential reinforced clostridial broth (DRCM) – Дифференциальный улучшенный бульон для роста клостридий |
500 |
27,5 |
|
105411 |
Reinforced clostridial medium (RCM) – Улучшенный клостридиальный бульон |
500 |
33,0 |
|
108191 |
Fluid thioglycolate medium – Тиогликолевая среда |
500 |
29,0 |
|
110259 |
DCA-agar- Дифференциальный клостридиальныйагар |
500 |
41,5 |
|
105264 |
TSN agar Perfringens selective agar – TSN агар для определения и подсчета сульфитредуцирующих клостридий в продуктах и сырье |
500 |
40,0 |
|
105410 |
Reinforced clostridial agar – Улучшенный клостридиальный агар |
500 |
50,0 |
|
110235 |
SPS-agar – Селективный SPS-агар сульфит-полимиксин- сульфадиазин |
500 |
40,0 |
|
110864 |
Sulfite iron agar base – Железо-сульфитный агар (основа) |
500 |
40,5 |
|
111972 |
TSC agar (tryptose sulfite cycloserine agar) base – Основа TSC агара; определение и подсчет сульфитредуцирующих бактерий |
500 |
42,0 |
|
100888 |
Clostridium perfringens selective supplement – Селективная флюорогенная добавка (циклосерин, 4-MUP)к TSC-агару для определения Cl.perfringens |
16 фл. |
|
Питательные среды для определения Vibrio spp., Vibrio parahaemolyticus
|
Кат.№ |
Наименование |
Кол-во, г/уп |
Расход среды, г/л |
|
101800 |
Alkaline Peptone Water – Щелочная пептонная вода |
500 |
20 |
|
110263 |
TCBS agar – Агар TCBS для селективного выделения Vibrio spp. |
500 |
88 |
Питательные среды для определения Campilobacter
|
Кат.№ |
Наименование |
Кол-во, г/уп |
Расход среды, г/л |
|
100068 |
Bolton Selective Enrichment Broth – Селективный бульон Болтона |
500 |
27,6 |
|
100079 |
Bolton Broth Selective Supplement – Селективная добавка к бульону Болтона |
16 фл. |
|
|
100070 |
Campylobacter Blood-Free Selective Agar – Селективный агар CCDA для кампилобактера (без крови) |
500 |
22,75 |
|
100071 |
CCDA Selective Supplement – Селективная добавка для агара CCDA |
16 фл. |
|
|
102248 |
Campylobacter selective agar base – Основа кампилобактер агара |
500 |
40 |
|
102249 |
Campylobacter selective supplement – Селективная добавка для кампилобактер агара |
16 фл |
|
|
104143 |
Singlepath Campylobacter - Экспресс-тест (20 мин) на кампилобактер |
25 тестов |
|
Питательные среды для определения E. coli
|
Кат.№ |
Наименование |
Кол-во, г/уп |
Расход среды, г/л |
|
114582 |
mEC-broth with Novobiocin – Модифицированный бульон EC с новобиоцином для исследования мясных продуктов |
500 |
36,7 |
|
109205 |
mCASO-broth+Novobiocin- Модифицированный бульон CASO с новобиоцином для исследования молочных продуктов |
500 |
33,0 |
|
109207 |
SMAC-agar (Sorbitol-MacCONKEYagar) - Агар Мак-Конки с сорбитолом |
500 |
51,5 |
|
109202 |
СТ-Supplement- Селективная добавка к SMAC-агару для выделения E.coli O157 |
16 фл. |
|
|
100060 |
CAYE Broth- бульон для индукции синтеза шигоподобных токсинов энтерогеморрагических E.coli |
100 |
39,8 |
|
100051 |
CAYE Broth Supplement – индуктор синтеза шигоподобных токсинов энтерогеморрагических E.coli |
16 фл. |
|
|
104141 |
Singlepath E. coli O157 – Экспресс-тест (20 мин) E.coli O157 |
25 тестов |
|
|
104144 |
Duopath Verotoxin – - Экспресс-тест (20 мин) на шигоподобные токсины STL1 и STL2 энтерогеморрагических E. coli |
25 тестов |
|
Питательные среды для определения легионелл
|
Кат.№ |
Наименование |
Кол-во, г/уп |
Расход среды, г/л |
|
110242 |
Legionella CYE Agar base – CYE агар (основа) - аналог среды Будрагдля для выделения легионелл |
500 |
60,0 |
|
110240 |
Legionella BCYE growth supplement – Ростовая добавка BCYE для выделения легионелл |
10 фл. |
1 фл./ 500мл |
|
110241 |
Legionella GVPC selective supplement – Селективная добавка BCYE для выделения легионелл |
10 фл. |
1 фл./ 500мл |
|
104147 |
Duopath Legionella – Экспресс-тест (20 мин) на Legionella pneumophila |
25 тестов |
|
Питательные среды для определения иерсиний
|
Кат.№ |
Наименование |
Кол-во, г/уп |
Расход среды, г/л |
|
116701 |
Yersinia selective enrichment broth – Селективный бульон для иерсиний |
500 |
38,7 |
|
116434 |
Yersinia selective agar – CIN-agar – Селективный агар для иерсиний |
500 |
58,5 |
|
116466 |
Yersinia selective supplement – Селективная добавка для CIN-агара |
16 фл. |
|
Питательные среды для определения бруцелл
|
Кат.№ |
Наименование |
Кол-во, г/уп |
Расход среды, г/л |
|
110676 |
Tryptosebroth - Триптозный бульон для культивирования требовательных патогенных микроорганизмов |
500 |
26 |
|
110490 |
Brucella agar- Бруцелла агар |
500 |
41 |
Питательные среды для определения лактат-ферментирующих клостридий, вызывающих порчу СЫРА
|
Кат.№ |
Наименование |
Кол-во, г/уп |
Расход среды, г/л |
|
101617 |
Bryant Burkey Broth with Resazurine and Lactate – Селективный бульон для выделения спор лактат- ферментирующих клостридий, вызывающих порчу сыра |
500 |
38,0 |
Питательные среды для определения микроорганизмов, вызывающих порчу СОКОВ
|
Кат.№ |
Наименование |
Кол-во, г/уп |
Расход среды, г/л |
|
107994 |
BAT-agar – среда для выявления Alicyclobacillus acidoterrestris |
500 |
29,0 |
Питательные среды для определения микроорганизмов, вызывающих порчу ПИВА
|
Кат.№ |
Наименование |
Кол-во, г/уп |
Расход среды, г/л |
|
100445 |
UBA-agar- Универсальный пивной агар |
500 |
55,0 |
|
110866 |
WL nutrient agar – Агар Валлерштейна для подсчета дрожжей и бактерий (в пивоваренном производстве) |
500 |
77,0 |
Питательные среды для контроля стерильности лекарственных препаратов
|
Кат.№ |
Наименование |
Кол-во, г/уп |
Расход среды, г/л |
|
100800 |
Tryptic soy (CASO) broth irradiated – Триптиказо-соевый бульон, сухая среда, стерилизованная облучением |
5000 |
30,0 |
|
108190 |
Thioglycolate broth – Тиогликолевая среда |
500 |
29,0 |
|
108190 |
Thioglycolate broth – Тиогликолевая среда |
5000 |
29,0 |
|
108191 |
Fluid thioglycolate medium– Жидкая тиогликолевая среда |
500 |
29,0 |
|
116761 |
Thioglycolate medium G for microbiology – Тиогликолевая среда для культивирования анаэробных, факультативно-анаэробных и анаэрофильных микроорганизмов и проведения тестов на стерильность |
500 |
29,0 |
Питательные среды для определения чувствительности к антибиотикам
|
Кат.№ |
Наименование |
Кол-во, г/уп |
Расход среды, г/л |
|
110293 |
MUELLER-HINTON Broth – Бульон Мюллер-Хинтон чувствительность микроорганизмов к антибиотикам |
500 |
21,0 |
|
105437 |
MUELLER-HINTON agar – Агар Мюллер-Хинтон для определения чувствительности микроорганизмов к антибиотикам |
500 |
34 |
|
105435 |
MUELLER-HINTON agar acc. to NCCLS – Агар Мюллер- Хинтон в соответствии со стандартом NCCLS для определения чувствительности микроорганизмов к антибиотикам |
500 |
38 |
Наборы и реактивы для окраски по Граму
|
Кат.№ |
Наименование |
Кол-во, г/уп |
|
111885 |
Gram-color – Набор для окраски по Граму; 5 фл.×500 мл |
5×500 |
|
101603 |
Gram-Color modified – Набор окраски по Граму модифицированный, без фенола, 5 фл.× 200 мл |
5×200 |
|
113301 |
Bactident Aminopeptidase – Тест-полоски для экспрессной дифференциации микроорганизмов на грам+ и грам- |
50 шт. |
|
104699 |
Immersion oil for microscopy – Иммерсионное масло для микроскопии |
100 мл/уп. |
Питательные среды для контроля парфюмерно-косметической продукции
Питательные среды для приготовления разведений
|
Кат.№ |
Наименование |
Кол-во, г/уп |
Расход среды, г/л |
|
111723 |
Casein-peptone Lecithin Polysorbate Broth (TAT Broth) – ТАТ-бульон; среда для разведения образцов косметики; пептон из казеина, лецитин, твин 20 |
500 |
25,0 |
|
822184 |
Tween 20 – Твин 20 |
500 мл |
|
Питательные среды для культивирования аэробных и факультативно-анаэробных микроорганизмов
|
Кат.№ |
Наименование |
Кол-во, г/уп |
Расход среды, г/л |
|
110404 |
Letheen Agar – Летиновый агар для подсчета микроорганизмов (среда с твином и лецитином) |
500 |
52,1 |
|
107324 |
Tryptic soy agar with polysorbate 80 and lecithin – Триптиказо-соевый агар с Твином 80 и лецитином |
500 |
45,7 |
|
822187 |
Tween 80 – Твин 80 |
500 |
|
Питательные среды для культивирования дрожжей и плесневых грибов
|
Кат.№ |
Наименование |
Кол-во, г/уп |
Расход среды, г/л |
|
105438 |
SABOURAUD-4% dextrose agar – Агар Сабуро 4% глюкозы |
500 |
65,0 |
|
110130 |
Potato dextrose agar – Картофельный глюкозный агар |
500 |
39,0 |
|
105398 |
Malt extract agar – Агар с солодовым экстрактом |
500 |
48,0 |
Среда для неселективного обогащения бактерий семейства Enterobacteriaceae, Pseudomonas aeruginosa, Staphylococcus aureus
|
Кат.№ |
Наименование |
Кол-во, г/уп |
Расход среды, г/л |
|
110405 |
Letheen Broth - Летиновый бульон для обнаружения микроорганизмов в присутствии ингибиторов |
500 |
37,6 |
Питательные среды для культивирования бактерий семейства Enterobacteriaceae
|
Кат.№ |
Наименование |
Кол-во, г/уп |
Расход среды, г/л |
|
105465 |
MacConkey agar – Агар Мак-Конки |
500 |
39,0 |
|
110275 |
VRBD agar – Глюкозный агар с кристаллическим фиолетовым и желчью |
500 |
39,5 |
Питательные среды для культивирования Pseudomonas aeruginosa
|
Кат.№ |
Наименование |
Кол-во, г/уп |
Расход среды, г/л |
|
105284 |
Cetrimide agar – Цетримидный агар |
500 |
44,5 |
Питательные среды для культивирования Staphylococcus aureus
|
Кат.№ |
Наименование |
Кол-во, г/уп |
Расход среды, г/л |
|
105406 |
BAIRD-Parker agar – Агар Байрд-Паркер |
500 |
58,0 |
|
103785 |
Egg yolk tellurite emulsion (sterile) - Стерильная желточно- теллуритная эмульсия |
10×50мл |
|
|
105404 |
Mannitol salt phenol-red agar – Маннит-солевой агар с феноловым красным |
500 |
108,0 |
Экспресс-тесты для определения ферментативной активности микроорганизмов
|
Кат.№ |
Наименование |
Кол-во в упак. |
|
113303 |
Bactident® E. coli – Набор для экспресс-дифференциации E. coli |
50 тестов |
|
113306 |
Bactident® Coagulase – Лиофилизированная кроличья плазма с ЭДТА для постановки коагулазного теста |
6×3 мл |
|
113301 |
Bactident Aminopeptidase – Тест-полоски для экспрессной дифференциации микроорганизмов на грам+ и грам-(определение L-аланил аминопептидазы) |
50 шт. |
|
113300 |
Bactident® Oxidase – Тест-полоски для определения наличия цитохром-оксидазы в микроорганизмах |
50 шт. |
|
111351 |
Bactident® Catalase Hydrogen peroxide 3% - Реактив для определения каталазы, перекись водорода 3% |
30 мл. |
|
111350 |
Bactident® KOVÁCS Indol reagent - Реактив Ковача |
30 мл |
|
113203 |
UV lamp 366 nm for microbiology – УФ лампа 366 нм для микробиологических анализов |
1 |
-Merck heipha - готовые стерильные агаризованные питательные среды в чашках Петри
Превосходное решение в приготовлении питательных сред. Технология производства компании MERCK позволяет гарантировать срок хранения до 6 месяцев. Чашки упакованы в кассеты по 5 штук. Упаковки по 20 и 480 чашек.

- Гранулированные и готовые к использованию стерильные питательные среды для валидации процесса наполнения (медиафил тест):
- триптон-соевый бульон классического состава и на основе растительного пептона;
- гранулированные стерильные среды в фасовке 500 г и 5 кг;
- готовые к использованию жидкие питательные среды в мягких пакетах 10 литров в тройной упаковке.

Узнайте больше
Ваше сообщение успешно отправлено. Спасибо.
